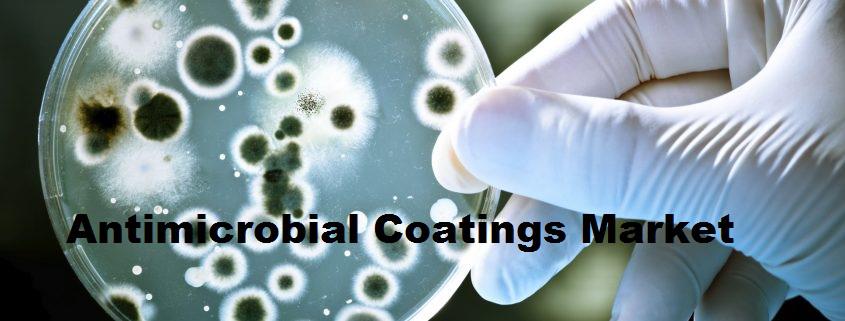

Press release
Antimicrobial Coatings Market Trends, Analysis by Regions, Type, Application, Market Drivers, Restraints, and Top Key Players – Global Forecast to 2023
Antimicrobial Coatings Market ResearchSummary:
Global Antimicrobial Coatings Market Review 2017-2018 Forecast to 2023 - Analysis by Chemical Type, Technology, Application, End-User, Industry Vertical, and Region’ into its vast depository of research reports. In the first section of the report, the market definition, market overview, product description, product scope, product characterization, and product specification has been discussed.
GET SAMPLE REPORT @ https://bit.ly/2Medrt6
The information presented in this report provides an overview of the latest trends and development plans, patterns, and policies observed in the global market. Moreover, the study provides an analysis of the latest events such as the technological advancements and the product launches and their consequences on the global Antimicrobial Coatings market. The global market also comprises the data accumulated from numerous primary and secondary sources.
The report firstly introduced the Antimicrobial Coatings basics: definitions, classifications, applications and market overview; product specifications; manufacturing processes; cost structures, raw materials and so on. Then it analyzed the world's main region market conditions, including the product price, profit, capacity, production, supply, demand and market growth rate and forecast etc. In the end, the report introduced new project SWOT analysis, investment feasibility analysis, and investment return analysis.
The Global Antimicrobial Coatings Market research report displays the market size, share, status, production, cost analysis, and market value with the forecast period 2018-2023. Besides, upstream raw materials, downstream demand analysis, consumption volume, and the market share by segments and sub-segments have also been mentioned. The research methodology of the market involves both primary as well as secondary research data sources. It commits different factors affecting Antimicrobial Coatings industry such as market environment, various policies of the government, past data and market trends, technological advancements, upcoming innovations, market risk factors, market restraints, and challenges in the industry.
More detailed information, please feel free to contact : https://bit.ly/2ABnxmB
Geographically it is divided Antimicrobial Coatings market into seven prime regions which are on the basis of sales, revenue, and market share and growth rate.
North America (United States, Canada and Mexico), Europe (Germany, France, UK, Russia and Italy), Asia-Pacific (China, Japan, Korea, India and Southeast Asia), South America (Brazil, Argentina, Colombia etc.), Middle East and Africa (Saudi Arabia, UAE, Egypt, Nigeria and South Africa)
The report typically features the competitive analysis of the global Antimicrobial Coatings market which uncovers the leading competitors involved in marketing and selling of market products. Readers of this report will get detailed and comprehensive information on the market. It additionally provides a precise analysis of the parent market based on the historical, current, and the future data, which will build the overall revenue and allows key players to make informed business decisions. The study reports further highlights on the developments, CAGR, innovations, plan executions, and dynamic structure of the market. Through SWOT (Strengths, Weaknesses, Opportunities, and Threats) and PEST (Political, Economic, Socio-cultural and technological) analysis help readers to accept the facts pertaining to the market layout.
Key questions answered in this report:
What will be the market size by the end of the forecast period?
What are the factors driving the growth of the market?
What are the trends and developments that are likely to drive the growth of the market?
Who are the key players operating in the market?
What are the challenges, threats, and opportunities faced by the leading players?
What are the strengths and weaknesses of the key players of the market?
About Us:
We at Garner Insights.com provide a comprehensive analysis by providing in-depth reports of the various market verticals. Our Mission is to provide a detailed analysis of the vast markets Globalwide backed by ricsh data. Decision makers can now rely on our well-defined data gathering methods to get the correct and accurate market forecasting along with detailed analysis.
Contact Us:
Mr. Kevin Thomas
Direct:
+1 513 549 5911 (US)
+44 203 318 2846 (UK)
Email: sales@garnerinsights.com
This release was published on openPR.
Permanent link to this press release:
Copy
Please set a link in the press area of your homepage to this press release on openPR. openPR disclaims liability for any content contained in this release.
You can edit or delete your press release Antimicrobial Coatings Market Trends, Analysis by Regions, Type, Application, Market Drivers, Restraints, and Top Key Players – Global Forecast to 2023 here
News-ID: 1160075 • Views: …
More Releases from Garner Insights

Geothermal Heating And Cooling Systems Market Analysis, Share, Growth, Trends, R …
Geothermal Heating And Cooling Systems Market Report 2020:
The research study is a valuable source of insightful data for all the business strategies. An in-depth depiction of the value chain and the distribution channel is provided in this study by the industry professionals. The Geothermal Heating And Cooling Systems Market study provides detailed information regarding the scope and application of the market, which helps in better understanding of the market. The…

In-Memory OLAP Database Market 2020 Emerging Trends by 2025 with major key Compa …
In-Memory OLAP Database Market Report 2020:
The research study is a valuable source of insightful data for all the business strategies. An in-depth depiction of the value chain and the distribution channel is provided in this study by the industry professionals. The In-Memory OLAP Database Market study provides detailed information regarding the scope and application of the market, which helps in better understanding of the market. The report on Global In-Memory…

Rectenna Market 2020 Trend, Share and Forecast to 2025 | Top Key PlayersCoolCAD …
Rectenna Market Report 2020:
The research study is a valuable source of insightful data for all the business strategies. An in-depth depiction of the value chain and the distribution channel is provided in this study by the industry professionals. The Rectenna Market study provides detailed information regarding the scope and application of the market, which helps in better understanding of the market. The report on Global Rectenna Market covers the various…

Bio-Based Chemical Market Trends, Growth, Opportunities, Scope & Detail Survey b …
Bio-Based Chemical Market Report 2020:
The research study is a valuable source of insightful data for all the business strategies. An in-depth depiction of the value chain and the distribution channel is provided in this study by the industry professionals. The Bio-Based Chemical Market study provides detailed information regarding the scope and application of the market, which helps in better understanding of the market. The report on Global Bio-Based Chemical Market…
More Releases for Antimicrobial
Antimicrobial Packaging Market: An Overview
Antimicrobial packaging is a rapidly growing segment within the packaging industry, designed to inhibit the growth of harmful microorganisms. This innovative solution is gaining attention due to its ability to prolong the shelf life of products, enhance food safety, and reduce waste. The application of antimicrobial agents in packaging materials offers significant benefits across various sectors, including food and beverage, pharmaceuticals, and personal care.
Market Size
The antimicrobial packaging market is expected…
Antimicrobial Peptides Beyond Traditional Antibiotics: The Antimicrobial Peptide …
Antimicrobial Peptides Market worth $532.02 Mn by 2031 - Exclusive Report by InsightAce Analytic Pvt. Ltd.
InsightAce Analytic Pvt. Ltd. announces the release of a market assessment report on the "Global Antimicrobial Peptides Market - (By Product (Plant Antimicrobial Peptides, Bacterial Antimicrobial Peptides, Animal Antimicrobial Peptides, Insect Antimicrobial Peptides), By Ailments (Pneumonia, Hepatitis, Bacterial infections, HIV), By Route of Administration (Topical, Subcutaneous, Intravenous), By End User (Pharma and Healthcare, Agriculture Industry,…
Antimicrobial Susceptibility Testing Market
Redding California,March 19, 2024 - Meticulous Research®, a distinguished leader in global market research, announces the release of its latest report titled "Antimicrobial Susceptibility Testing Market." This comprehensive study provides valuable insights into the market landscape, forecasting significant growth and pivotal trends shaping the industry landscape.
Download free sample report here: https://www.meticulousresearch.com/download-sample-report/cp_id=5062
The Antimicrobial Susceptibility Testing Market is projected to burgeon to $5.99 billion by 2028, exhibiting a robust CAGR of approximately…
Veterinary Antimicrobial Susceptibility Testing Market: Navigating Growth Amidst …
The Veterinary Antimicrobial Susceptibility Testing Market is poised for significant growth in the coming years, as per a recent report by Transparency Market Research. With a projected CAGR of nearly 7% from 2022 to 2032, the market is expected to reach a valuation of nearly US$ 76.2 billion by the end of the forecast period, up from around US$ 37.6 billion in 2021.
The market growth is primarily driven by several…
Antimicrobial Plastics Industry 2022-2026
The antimicrobial plastics market is projected to reach USD 66.7 billion by 2026, at a CAGR of 10.8% from USD 40.0 billion in 2021.
Download FREE Sample Research Report of Antimicrobial Plastics Market @ https://www.reportsnreports.com/contacts/requestsample.aspx?name=371217
The report provides a comprehensive analysis of company profiles listed below:
• DuPont De Nemours Inc. (US)
• BASF SE (Germany)
• Microban International (US)
• Sanitized AG (Switzerland)
• BioCote Limited (UK)
• Avient Corporation (US)
• King Plastic Corporation (US)
• Milliken Chemical (US)
• Parx Plastics N.V (Netherlands)
"The inorganic additive…
Antimicrobial Additives Industry 2022-2026
The antimicrobial additives market is estimated to grow to USD 5.5 billion by 2026 from USD 4.0 billion in 2021, at a CAGR of 6.6%.
Download FREE Sample Research Report of Antimicrobial Additives Market @ https://www.reportsnreports.com/contacts/requestsample.aspx?name=5462394
The report provides a comprehensive analysis of company profiles listed below:
• BASF SE (Germany)
• DuPont De Nemours (US)
• Microban International (US)
• Sanitized AG (Switzerland)
• LyondellBasell (Netherlands)
• Avient Corporation (US)
• Biocote (UK)
• RTP Company (US)
• Milliken Chemical (US)
There has been massive industrial growth in…